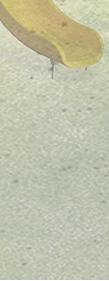

PORTFOLIO
John Chen.
Wei-Han Chen (John)

+886-983-792092
johnjohn8430@gmail.com
陳 偉翰
Education
Ming Chi University of Technology
Industrial Design
New Taipei City, Taiwan | 2015-2018
Tunghai University
Department of Architecture M.Arch1
Taichung, Taiwan | 2020-present
Work Experience
2017 Sep 2018 Sep 2022 Sep 2022 July
Award
栐欐國際設計室內裝修股份有限公司
設計助理
張景堯聯合建築師事務所
暑期實習生
2017 康寧創新家 創新應用競賽 優等獎
2018 台灣工藝設計研究中心 工藝新趣新工藝人才入籍計畫
2018 明志科技大學工讀實習表現優異
2019 金點新秀獎 入圍獎
2019 新一代設計產學合作企業大獎 銀獎
Software
Adobe Suite
Adobe Lightroom
Adobe photoshop
Adobe Illustrator
Adobe Indesign
CAD & Render
SketchUp
Rhino
Enscape
Revit
V-ray AutoCAD
Public building design
公共建築
2 1 4 3
千越大樓改造計畫-社區運動中心
Sport and Culture Center
綠川藝文中心-綠廊
Arts and Culture Center
Planting Center
Kindergarten
銀聯幼兒園 東海植栽中心
千越大樓改造計畫-社區運動中心
Sport and Culture Center


Activity status









SITE 綠帶-晨間使用範圍 使用時間 300M 450M 綠帶-日間使用範圍 使用時間 300M 450M SITE 綠帶-夜間使用範圍 使用時間 300M 450M SITE 廣場-晨間使用範圍 使用時間 300M 450M SITE 廣場-日間使用範圍 使用時間 300M 450M SITE 廣場-夜間使用範圍 使用時間 300M 450M SITE 廣場&綠帶 晨間使用範圍 使用時間 300M 450M SITE 廣場&綠帶 晨間使用範圍 使用時間 300M 450M SITE 廣場&綠帶 夜間使用範圍 使用時間 300M 450M SITE 晨間 日間 晚間






晨間使用 居民漫步路線延伸 300M 450M SITE 晨間使用 居民運動廣場 停留空間 300M 450M SITE 日間使用 綠意進入基地內 延伸 300M 450M SITE 日間使用 開闊空間節點 延伸 300M 450M SITE 夜間使用 活動的連結 串聯 300M 450M SITE 夜間使用 廣場空間的連結 串聯 300M 450M SITE 居民漫步路線延伸 綠意進入基地 廣場空間的連結 活動的連結 開闊空間節點 居民運動廣場 路徑 延伸 串聯 串聯 延伸 停留



Gym Cafe Parking Court Community Info Tea G Caf Sight 社區 飲食 居民路徑 遊客路徑 視線




01.B1F PLAN 02.1F PLAN 03.2F PLAN 01 02 03 B B A A











01 02 03







01.3F PLAN 02.4F PLAN 03.5F PLAN 04.6F PLAN 05.7F PLAN 06.8F PLAN 04 05 06

01


02 01. AA Section 02. BB Section






綠川藝文中心-綠廊 Arts and Culture Center
目前在綠川這個地方雖有設置一個小型廣場,但在白天時基本上都是經過此地 的人們,鮮少會有人停留在此處.所以運用多種功能的共享空間讓人們能夠在 這舉辦活動進而成為聚集的場所,藉此來帶動當地社區的活躍度.以及製造休 憩的空間讓來綠空步道的人流能夠停留在此,成為都市中停留的節點.


因應基地的環境,將藝廊、咖啡廳、接梯教室 等公共空間放置於面向廣場的位置,且將私人 住宅置於靠綠川的位置,避免日常生活受鐵道 噪音影響.

1F 2F 3F 4F 5F
住宅 垂直動線 住宅 住宅 藝廊 咖啡廳 教室 階梯教室


01 05 06 01.東北向外觀 02.咖啡廳戶外區 03.二樓中庭 04.剖面圖 05.一樓平面圖 06.二樓平面圖 07.三樓平面圖 08.四樓平面圖











室內 02 03 04 07 08


09 10 11 09.五樓平面圖 10.地下一層平面圖 11.三樓階梯教室 12.活動空間 13.活動空間 14.藝廊 15.二、三樓樓梯















12 14 13 15 立面圖 AA SECTION BB SECTION
東海植栽教學中心
Planting Center



1 2 3
在東海二校區茂密的樹林當中有許多小住宅,是教師們的居住地。靜謐的 社區與校園中人來人往的景象形成對比。在東海教師宿舍群中每一戶住宅 前都有屬於自己的前院,有的住戶會利用植物擺設來營造綠意融入周遭的 環境。因此,在這樣一個與自然環境息息相關的社區當中,藉由植物教學

中心,讓住戶們能夠有互相交流植栽與學習的機會。
1.教師休閒中心
2.植栽教學中心
3.教師宿舍

全區配置圖



一層平面圖
1.入口
2.半戶外休憩空間
3.教學空間
4.觀水端景
5.中庭
6.林中步道
7.戶外植栽觀賞區
1 2 3 4 5 6 7 8
8.水上平台

 二層平面圖
1.植栽觀賞區
2.工作室
二層平面圖
1.植栽觀賞區
2.工作室
1 2 3
3.儲藏間



AA剖面圖


銀聯幼兒園
Yínián kindergarten


將主要的量體放在整個基地的角落位置,藉著量體和基地邊界,留出較開放的大門前廣場和幼兒園內 部較私密的戶外遊戲空間。在整個建築中也有三個主要的軸向,除了地亦清楚的空間功能外,也對基 地的環境做對應。在二層有戶外的露台,作為多功能的空間,讓小朋友們能眺望周遭的都市環境,滿
足小還們的好奇心,也可以在上面盡情的玩耍和奔跑。
整個建築是一個個學習角的集合。從室外到室內,孩子們可以奔跑在空
間當中,或聚集在各自最喜歡的地方。創造更好的學習環境的同時也營 造了更好的社區環境。


















































































1 2 3 4 4 5 6 7 8 9 10 11 12 13 14 2 2 2
1.大廳
2.教室
3.情緒轉換空間
4.閱讀遊戲角落
5.洽談區
6.教師辦公室
7.保健室
8.配膳房
9.停車區
10.木屑區
11.沙坑區
12.遊戲區
13.苗圃區
1F PLAN
14.情緒轉換角落
















































 1.閱讀遊戲區
2.體感教室
3.教師室
4.教保室
5.教室
1.閱讀遊戲區
2.體感教室
3.教師室
4.教保室
5.教室
2F PLAN 1 5 6 5 3 3 4 2
6.戶外活動平台

































































Housing design
社會住宅&個人住宅 社會住宅-層埕
1 2
housing
個人住宅-新社 Social
Housing
社會住宅-層埕
Social housing
層層量體的堆疊和不同的視角,串連居民們對於廟埕的情感,體驗在都市中的寧靜和諧。

通風綠化
在整體的量體配置上配合了基地的軸線和對於土地公廟的對應,主要分成了兩棟建築物
面層上做連通,能方便社區的管理以及居民便捷度。
空間配置上主要將公共設施放置在一、二層較靠土地公廟的位置,並且也有空中的廊道去聯通兩邊
的公共空間,讓居民們能有較獨立的戶外露台空間去使用及舉辦社區活動進而交流社區居民的情感。
在靠東邊的建築物設計了一座能直達屋頂層的垂直動線能讓人們到達不同的樓層,也有留設了戶外
的露台空間能幫助建築物的通風,也能提供不同的視角去觀看都市的天際線 。
基地軸線 量體交界處整合 地面層連通 空中廊道
,並且在地
 1.大廳
2.商店
3.多功能遊戲空間
4.休憩區
5.洗衣間
6.垃圾間
7.托嬰中心
8.涼亭
1.大廳
2.商店
3.多功能遊戲空間
4.休憩區
5.洗衣間
6.垃圾間
7.托嬰中心
8.涼亭
1 2 3 4 5 6 7 8 9
9.廟埕廣場
正門的入口較深,在回家的路線上做了轉折的動 作,在路途當中能夠看到水景 ,讓居民們能夠轉




換平靜的心情回到家中。在大廳的中間有個休憩 的空間讓人們能夠舒服的坐在市內觀看外面的景 色。

1.健身房 2.共享廚房 3.乒乓球室 4.撞球室
2F PLAN 1 2 3 4 5 6 7 7
5.托嬰中心 6.廣場 7.休憩區








Studio 一房型 二房型 STANDARD PLAN 一房型 二房型-1 二房型-2 Studio房型




 1.曬衣區
2.空橋
3.休憩區
1.台電配電室
2.消防機房
3.發電機房
4.電信機房
5.水箱
7F PLAN
1.曬衣區
2.空橋
3.休憩區
1.台電配電室
2.消防機房
3.發電機房
4.電信機房
5.水箱
7F PLAN
2 3 1 1 1 2 3 4 5
B1F PLAN




籃球場 廟埕廣場 廟埕廣場、公園 街區景色 都市景色
AA section













































個人住宅-新社 Housing

1 2 3 4 6 7 9 8 10 5 0 120 240 350
一樓平面圖
1.玄關
2.閱讀區
3.車庫
4.父母臥室
5.公用衛浴
6.臥室
7.臥室
8.主臥室
9.更衣室
10.泳池
1 2 3 4 6 7 5
地下一樓平面圖
1.客廳
2.餐廳
3.廚房
4.工作陽台
5.儲藏室
6.工作室
7.廁所





Internship
Render Case Studies 1











Photograph
攝影作品






Thanks for watching !



















































































 二層平面圖
1.植栽觀賞區
2.工作室
二層平面圖
1.植栽觀賞區
2.工作室

1.閱讀遊戲區
2.體感教室
3.教師室
4.教保室
5.教室
1.閱讀遊戲區
2.體感教室
3.教師室
4.教保室
5.教室













































 1.大廳
2.商店
3.多功能遊戲空間
4.休憩區
5.洗衣間
6.垃圾間
7.托嬰中心
8.涼亭
1.大廳
2.商店
3.多功能遊戲空間
4.休憩區
5.洗衣間
6.垃圾間
7.托嬰中心
8.涼亭

















 1.曬衣區
2.空橋
3.休憩區
1.台電配電室
2.消防機房
3.發電機房
4.電信機房
5.水箱
7F PLAN
1.曬衣區
2.空橋
3.休憩區
1.台電配電室
2.消防機房
3.發電機房
4.電信機房
5.水箱
7F PLAN







































































